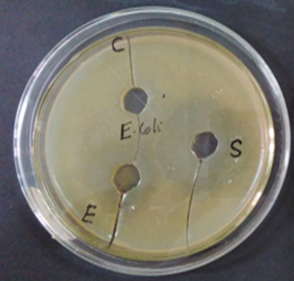
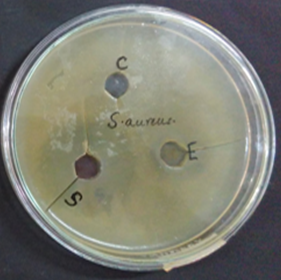

Int J Curr Pharm Res, Vol 12, Issue 6, 74-76Original Article
ANTIMICROBIAL EVALUATION OF ETHANOLIC EXTRACT OF SELECTED SEED SHELLS
MOUSHUMI BAIDYA1,2, ANBU J.3, SEMIMUL AKHTAR4, SIPRA SARKAR2, SUDIP KUMAR MANDAL5*
1Department of Pharmaceutical Technology, JIS University, Agarpara, Kolkata 700109, West Bengal, India, 2Department of Pharmaceutical Technology, Brainware University, Barasat 700125, West Bengal, India, 3Department of Pharmacology, Faculty of Pharmacy, M. S. Ramaiah University of Applied Sciences, MSR Nagar, Bangalore 560054, Karnataka, India, 4Shri Ram Murti Smarak College of Engineering and Technology (Pharmacy), Bareilly, Uttar Pradesh, India, 5Department of Pharmaceutical Chemistry, Dr. B. C. Roy College of Pharmacy and Allied Health Sciences, Durgapur 713206, West Bengal, India
Email: gotosudip79@gmail.com
Received: 10 Jul 2020, Revised and Accepted: 08 Sep 2020
ABSTRACT
Objective: The study was undertaken to evaluate the antimicrobial activity of ethanolic extract of polyherbal seed shells.
Methods: The seed of Momordica charantia, Manikara zapota, Emblica officinalis, Syzygium cumini, collected from the local market, Mathikere, Bangalore, India. Ethanolic extract was prepared from the dried seed powders using solvent 80% ethanol. Initially, antimicrobial activity of the extract was performed by agar well diffusion method against two bacterial strains (Escherichia coli, and Staphylococcus aureus) and two fungal pathogens (Aspergillus niger and Candida albicans).
Results: The antimicrobial study results revealed that the test extract was strongly inhibited the growth of bacteria, whereas it was not inhibited the growth of fungal organisms used in this study.
Conclusion: The results suggest that ethanolic extract of seeds possess antimicrobial properties which can be used for the treatment of infectious diseases.
Keywords: Antibacterial, Antifungal, Polyherbal seeds extract
© 2020 The Authors. Published by Innovare Academic Sciences Pvt Ltd. This is an open access article under the CC BY license (http://creativecommons.org/licenses/by/4.0/)
DOI: http://dx.doi.org/10.22159/ijcpr.2020v12i6.40287. Journal homepage: https://innovareacademics.in/journals/index.php/ijcpr
INTRODUCTION
Traditional herbal medicines are observed to have been given a significant amount of attention in global health debates. It was found by the world health organization (WHO) that more than 80% of the world’s population is dependent on traditional medicine for their primary healthcare needs. In China, traditional herbal medicine played a prominent role in the strategy to contain and treat acute and chronic diseases [1].
About 80% of the African population actively uses some form of traditional medicine and the worldwide annual market value of these products approaches as high as 60 billion US$. Many anticipate that traditional herbal medicine research will play a crucial role in global health [2]. It is speculated that the accumulation of this vast knowledge on the usage of plants to cure various illnesses was carried out in regions where the use of plants is still given a lot of importance.
The medicinal value of plants is governed by some of its chemical substances that afflict a definite physiological action on the human body. The most significant of these chemical bioactive substances inside plants are alkaloids, flavonoids, tannins and phenolic compounds [3]. The use of medicinal plants as traditional medicines is a well-known practice in rural areas of myriads of developing countries [4, 5]. Healers that use traditional medicines claim that their medicines are cheaper and more effective than modern medicines. In many developing countries, low-income people such as farmers, people hailing from small isolated villages and native indigenous communities use folk medicine to treat common infections [6].
The phytochemical research based on ethnopharmacological information is evaluated as an effective approach in the discovery of new anti-infective agents in higher plants [7]. Microbes are capable of invading our body and about 1% of bacteria are very harmful, thus making us ill by causing many infectious diseases such as flu and measles. Many observations strongly suggest that microbes may contribute too many non-infectious chronic diseases such as various forms of coronary heart diseases and cancer. Different micro-organisms cause different diseases and they are called pathogens. A pathogen is a microorganism that carries the potential to cause a certain disease. A Disease is identified when an infection causes damage to an individual’s vital functions. Staphylococcus aureus and group A β-hemolytic streptococci are identified as the most common bacterial skin pathogens, whereas Herpes simplex is the most common viral skin disease and of the dermatophytic fungi, Trichophyton rubrum is the most predominant cause of skin and nail infections [8].
Nowadays, the growing incidence of microbial resistance with marketed antimicrobial drugs is a serious problem. So, there is an urgent need to develop a newer class of drugs to treat microbial infections [9-13]. The synthetic drugs are used to cure the disease, but due to their toxicity and adverse effects, the use of herbal remedies predominates. The present study is mainly focused on the process of extraction and evaluation of the antimicrobial activity of ethanolic extract of polyherbal seed shells (EEPSS).
Hence, in order to identify a better herbal-based antimicrobial and anthelmintic drug, the current experiment was designed. Literature revealed that the seed shell extract used in this study had yet not been screened for its antimicrobial activity. Therefore, the objective of this work was to explore the antimicrobial properties of selected seed shell extract.
MATERIALS AND METHODS
Drugs and chemicals
Ethanol (changshu yangyuan chemical), Gentamycin (crystal pharma), Micanazole (medico remedies pvt.ltd.)
Plant material
The fruits of Momordica charantia, Manilkara zapota, Emblica officinalis and Syzygium cumini were collected from the local markets of Bangalore, India. The well-ripened fruits were selected, seeds were isolated and kept for drying. The shells of seeds were collected and powdered for further process of extraction.
Preparation of ethanolic extract
100 g (25g/each) mixture of four different seed shells was macerated with 400 ml of ethanol for 72 h with intermittent shaking. Then it was filtered through Whatmann No.1 filter paper, dried until a constant dry weight of extract obtained and the residue was stored at 4 °C for further screening of antimicrobial activity.
Microorganisms
Ethanolic extract of polyherbal seed shells was screened against a total of two bacterial strains and two fungal strains. The bacterial test organisms Staphylococcus aureus (ATCC 25923) and Escherichia coli (MTCC 1652); fungal test organisms Candida albicans (MTCC 227) and Aspergillus niger (MTCC 2425) were taken from the Department of Microbiology, Faculty of Pharmacy, MSRUAS, Bangalore.
Experimental design
Antimicrobial screening
Preparation of inoculum
Stock cultures were maintained at 4 °C on slopes of nutrient agar. Active cultures for experiments were prepared by transferring a loopful of cells from the stock cultures to test tubes of nutrient broth for bacteria and Sabouraud dextrose broth (SDB) for fungi that were incubated without agitation for 24 h at 37 °C and 25 °C, respectively. The cultures were diluted with fresh nutrient broth and Sabouraud dextrose broth to achieve optical densities corresponding to 2.0 X 106 colony forming units (CFU/ml) for bacteria and 2.0 X 105 spore/ml for fungal strains.
Antimicrobial susceptibility test
Disc diffusion method was used to determine the antimicrobial activity. Nutrient broth and Sabouraud Dextrose Broth (SDB) were used as a medium for bacterial and fungal strains, respectively. Pure tested bacterium was first sub-cultured in nutrient broth at 37 °C for 24 h and fungi were first sub-cultured in saboured dextrose broth at 27 °C for 48 h. 10 ml of sterile assay media was added to each petridish with slow shaking [14, 15].
The petridishes with the bacterial and fungal cultures were incubated at 37 °C for 24 h and 27 °C for 48 h, respectively. Positive control experiment was carried out by gentamycin (30µg/ml) and miconazole (30µg/ml) for bacteria and fungi, respectively. The assessment of antimicrobial activity was assessed based on the diameter of the inhibition zone (ZOI) formed [16, 17].
RESULTS AND DISCUSSION
In the present investigation, two bacterial strains and two fungal pathogens were tested to determine the antibacterial and antifungal activity of EEPSS. Ethanolic extract of polyherbal seed shells at a concentration of 100 µg/ml showed a minimum of 24 mm inhibition against Escherichia coli and 22 mm inhibition against Staphylococcus aureus but did not show any inhibition against fungal pathogens. Standard drug at a concentration of 30 µg/ml showed a minimum of 38 mm inhibition against Escherichia coli and 35 mm inhibition against Staphylococcus aureus; 20 mm inhibition against Aspergillus niger and 26 mm inhibition against Candida albicans.
The antimicrobial activities of EEPSS against microorganisms examined in the present study and their potency were quantitatively assessed by the zone of inhibition (ZOI) and zone diameters.
The results (in table 1 and fig. 1) of the antimicrobial screening of the crude seed extracts of all species of plants showed promising activity against tested bacteria. The tested seed extracts were most active against gram-positive microorganisms than gram-negative microorganisms.

2

3

4
Fig. 1: Antimicrobial activity of EEPSS (C= Control, E= Extract, S= Standard; 1: E. coli, 2: S. aureus, 3: A. niger,4: C. albicans)
Table 1: Antimicrobial activity of EEPSS
| Groups | Concentration (µg/ml) |
Bacteria | Fungi | ||
| E. coli | S. aureus | C. albicans | A. niger | ||
| ZOI (mm) | ZOI (mm) | ZOI (mm) | ZOI (mm) | ||
| Control | --- | 0 mm | 0 mm | 0 mm | 0 mm |
| EEPSS | 100 | 24 mm | 22 mm | 0 mm | 0 mm |
| Gentamicin | 30 | 38 mm | 35 mm | --- | --- |
| Miconazole | 30 | --- | --- | 26 mm | 20 mm |
(EEPSS: Ethanolic extract of polyherbal seed shells)
CONCLUSION
The result of the present study supports the traditional use of the studied EEPSS in the treatment of microbial infections. The results suggest that ethanol extract of seeds possess antibacterial properties which can be used as a harmless and safe drug for the treatment of infectious diseases after their toxicological study. Further studies are required to identify the active constituents responsible for antibacterial activity and to establish their mechanisms of actions for developing newer antibiotics in future.
ACKNOWLEDGEMENT
Authors are grateful to Dr. V. Madhavan, Dean, Faculty of Pharmacy, M. S. R. U. A. S., Bangalore, for providing all the facilities to carry out this research work.
FUNDING
Nil
AUTHORS CONTRIBUTIONS
All the authors have contributed equally.
CONFLICT OF INTERESTS
Declared none
REFERENCES
Lobo DA, Velayudhan R, Chatterjee P, Kohli H, Hotez PJ. The neglected tropical diseases of India and South Asia: a review of their prevalence, distribution, and control or elimination. PLoS Negl Trop Dis 2011;5:1222.
Stephenson LS, Latham MC, Ottesen EA. Malnutrition and parasitic helminth Infections. Parasitology 2000;121:23-38.
Brooker S. Estimating the global distribution and disease burden of intestinal nematode infections: adding up the Numbers-a review. Int J Parasitol 2010;40:1137-44.
Strunz EC, Addiss DG, Stocks ME, Ogden S, Utzinger J, Freeman MC. Water, sanitation, hygiene, and soil-transmitted helminth infection: a systematic review and meta-analysis. PLoS Med 2014;11:1001620.
Utzinger J, Raso G, Brooker S, De Savigny D, Tanner M, Ornbjerg N, et al. Schistosomiasis and neglected tropical diseases: towards integrated and sustainable control and a word of caution. Parasitology 2009;136:1859.
Jia TW, Melville S, Utzinger J, King CH, Zhou XN. Soil-transmitted helminth reinfection after drug treatment: a systematic review and meta-analysis. PLoS Negl Trop Dis 2012;6:1621.
Sandhu DS, Heinrich M. The use of health foods, spices and other botanicals in the Sikh community in London. Phytother Res 2005;19:633-42.
Gupta MP, Solis PN, Calderon AI, Guionneau Sinclair F, Correa M, Galdames C, et al. Medical ethnobotany of the teribes of bocas del toro, panama. J Ethnopharmacol 2005;96:389-401.
Mandal SK. Indanyl analogs as potential antimicrobial agents. Asian J Pharm Clin Res 2018;11:278-80.
Roy S, Bose S, Sarkar D, Mandal S, Sarkar S, Mandal SK. Formulation and evaluation of anti-acne gel containing Murraya koeinigii extract. Int J Curr Pharma Res 2020;12:108-13.
Mandal SK, Pal H, Pal I, Bose S. Biological potential of Elephantopus scaber linn. Int J Pharm Sci Rev Res 2018;50:130-4.
Bose S, Mandal SK, Hossain P, Das A, Das P, Nandy S, et al. Phytochemical and pharmacological potentials of Agaricus bisporus. Res J Pharm Tech 2019;12:3811-7.
Mondal A, Bose S, Banerjee S, Patra J, Malik J, Mandal SK, et al. Marine cyanobacteria and microalgae metabolites-a rich source of potential anticancer drugs. Mar Drugs 2020;18:476.
Chakraborty GS. Antimicrobial activity of Chlorophytum borivilianum leaves. Indian Drugs 2009;46:579.
Rastogi T, Ghorpade DS, Deokate UA, Khadabadi SS. Studies on antimicrobial activity of Boswellia serrata, Moringa oleifera and Vitex negundo: a comparison. Res J Pharmacog Phytochem 2009;1:75-7.
Nithya M, Ragavendran C, Natarajan D. Antibacterial and free radical scavenging activity of a medicinal plant Solanum xanthocarpum. Int J Food Prop 2018;21:313-27.
Prakash SB, Sharmistha P, Kumar AR. Antibacterial activity of methanolic extract of roots of Caesalpinia pulcherrima. Int J Chem Sci 2009;7:16-8.